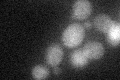
YCL039W
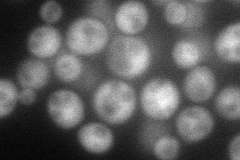
YCL039W
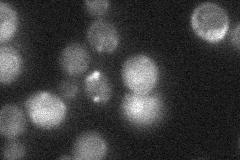
YCL039W
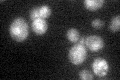
YCL039W

View description
Protein of unknown function, involved in proteasome-dependent catabolite inactivation of fructose-1,6-bisphosphatase; contains six WD40 repeats; computational analysis suggests that Gid7p and Moh1p have similar functions
Localization:
Intensity:
Fold change:
Significance:
-
C’ GFP library in SD
cytosol22.19 -
N' NOP1pr-GFP in SD
cytosol61.1576 -
N' TEF2pr-mCherry in SD

nucleus76.6451 -
N' NATIVEpr-GFP in SD
punctate22.2999 -
N' TEF2pr-VC and Cyto-VN in SD

#N/A0 -
C’ GFP library in SD+DTT

cytosol31.541.42Yes -
C’ GFP library in SD+H2O2

cytosol27.831.25No -
C’ GFP library in Starvation Media
nucleusN/AN/AYes -
C’ GFP library on the background of Pup2-DaMP

cytosol -
C’ GFP library on the background of CCT mutant

cytosol27.78791.25175No
